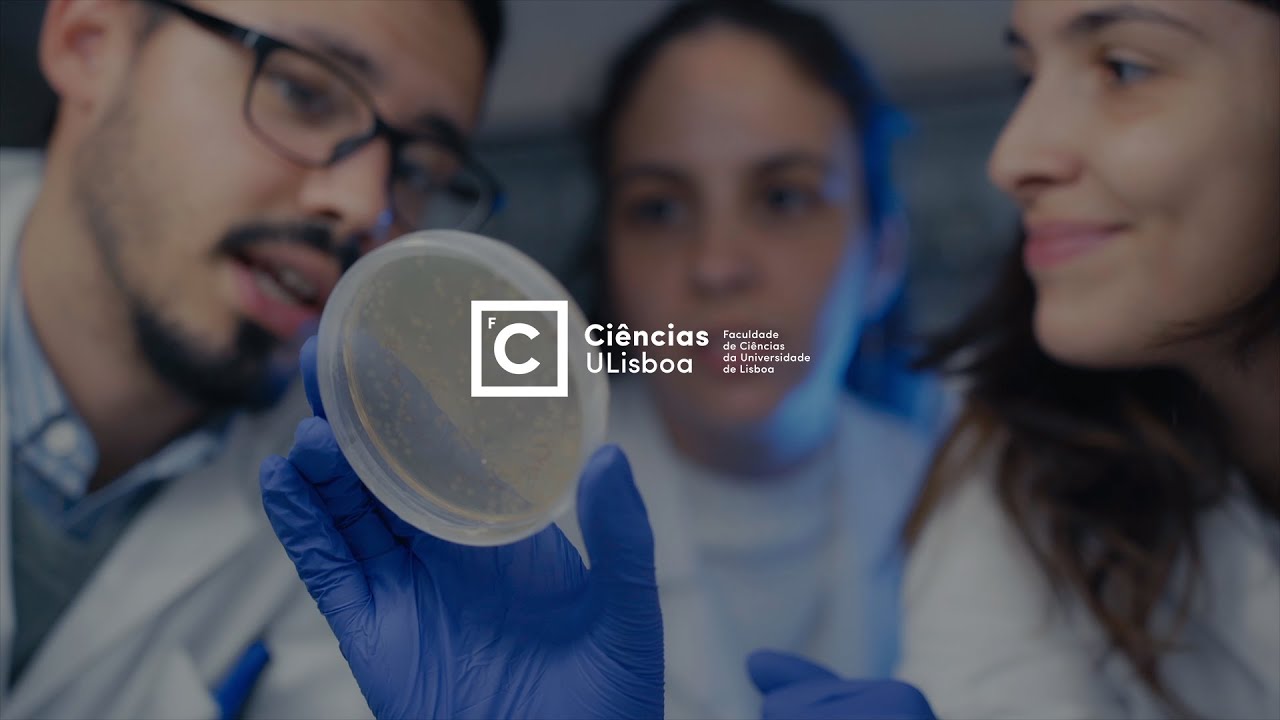
Faculdade de Ciências da Universidade de Lisboa

Olá a todos eu sou diretor da licenciaturas clássicos estudos clássicos é o nome normalmente damos ao estudo das civilizações que desenvolveram no mar mediterrâneo mais ou menos a partir do ano 1000 antes da era Cristã isto implica o estudo das duas principais línguas de cultura e de comunicação que aqui foram então utilizadas o grego antigo e o latim bem como dos seus textos muitos deles considerados ainda hoje obras-primas do génio humano como os problemas homéricos as tragédias gregas ou os textos de vigilância Além disso aqui em Lisboa estudamos também a arte a mitologia ouvida cotidiana
desse mundo longínquo o mundo clássico foi muito cheio contradições onde os textos e paisagens da mais extraordinária e beleza conviviam com os exemplos mais terríveis de crueldade escravatura da desigualdade social da miséria de violência de gênero em clássicas queremos também hoje falar sobre estas coisas porque elas nos ajudam a compreender muito melhor presente estamos ainda concentrados a investigar a Previdência da antiguidade clássica todo mundo pós clássico desde a idade média à contemporaneidade e de facto Praticamente tudo o que o ser humano produziu no mundo ocidental da arte a literatura do teatro arquitetura e até mesmo
do cinema à televisão feu inclusive até os dias de hoje imitando os temas clássicos o criticando e Desafiando os modelos antigos e é por isso que estudaste os clássicos é hoje no desafio extraordinário para aqui concorrem saberes muito diversos que vão desde essa história a linguística da arqueologia a literatura da epigrafia A Arte da filosofia a religião que permitem também a aquisição diversificada de competências com potencial imenso de aplicação na nossa sociedade por isso fazer a licenciaturas clássicos permita a partir do estudo da realidade grega e romana obter uma formação diversificada em Ciências Sociais e
humanidades que habilita aos seus alunos mais tarde no segundo ciclo a poderem escolher praticamente qualquer mestrado das literaturas à história da ciência política a sociologia eu acho tão cultural e claro a estudar aqui connosco no nosso próprio mestrado em uns bons estudos clássicos eles muito interessamos por alguns curiosos com vontade de fazer perguntas muitas perguntas nós não vamos ter respostas para tudo mas juntos poderemos procurar